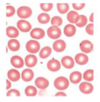

Morphology/Histo Block I Flashcards
normal red cell morphology
central pallor no more than 1/3 of diameter
coloring of RBC

normochromic RBCs
coloring of RBC

hypochromic RBCs, lack of Hgb (large central pallor)
what is abnormal about the RBCs

- microcytic: small RBC; smaller than nucleus of small lymphocyte; low MCV
ex) iron deficiency or hemoglobinopathies
what is abnormal about the RBCs

- macrocytic: large RBC; larger than a small lymphocyte nucleus; large MCV
ex) vitamin B12 or folic acid deficiency
what is seen here

White Cells in Peripheral Blood
GRANULOCYTES:
- Neutrophil: multilobed nucleus, clear/granular cytoplasm ; most abundant WC
- Basophil: spectacular large/blue-black granules, multilobed nucleus
- Eosinophil: 2-3 nuclear lobes, reddish granules
Monocyte: mature in marrow, travel to tissues via blood (where they are called macrophages)
- large with indented/folded nucleus
- no nucleoli visible
- may contain vacuoles/granules
- part of innate immune system
Lymphocyte: coarse chromatin
-part of adaptive immune system
what type of white cell is this?

neutrophil
what type of white cell is this?

eosinophil
what type of white cell is this?
band
(neutrophil where nucleus hasn’t segmented yet)

what type of white cell is this?

basophil
what type of cell is this

-mononuclear cell
Small lymphocyte: round nucleus with coarse, condensed chromatin, no visible nucleoli
- nucleus just about same size as normal RBC
- cytoplasm: blue
what type of cell is this

mononuclear cell
Atypical (reactive) lymphocytes: larger than small lymphocytes
- abundant pale blue cytoplasm without granules
- large round oval nucleus with condensed chromatin
- edge of reactive lymphocyte is indented by surrounding RBCs
- associated with viral infection
what type of cell is this

mononuclear cell
Large granular lymphocytes (NK, natural killer cells): cyotoxic lymphocyte that somewhat resemble reactive lymphocytes
- distinguished by prominent cytoplasmic granules
- major component of innate immune system
- major role in rejection of tumors & viral infected cells
- kill cells by releasing contents of their granules; inducing apoptosis
what cells are denoted by the arrows?

Platelets in Peripheral Blood: small, specialized blood cells important for initiating clotting process & maintenance of vascular integrity ; usually about 25% diameter of a RBC, no nucleus, specialized granules
-born in bone marrow from fragmentation of megakaryocyte ; live 7-10 days
what pathology is this

classic appearance of iron deficiency anemia
(microcytic, hypochromatic- large central pallor)
what pathology is this

sideroblastic anemia
arrowhead: normal sideroblast
long arrow: ringed sideroblast (iron stuck in mitochondria in ring around nucleus)
what pathology is this

arrowheads: basophilic stippling
most common in chronic lead poisoning
what does this depict

normal RBCs
- red/pink cytoplasm in Wright-Giemsa stain
- smooth round contours
- binconcave disk shape (due to extra membrane)
- central pallor ~1/3 diameter of cell
- ~7-8uM in diameter
- similar size to nucleus of small lymphocyte
erythrocyte development

Pronormoblast: earliest red cell precursor identifiable in bone marrow
- large cell with round nucleus; uncondensed chromatin; visible nucleoli; rim of dark blue cytoplasm
- no granules
- perinuclear clearing visible at 1 oclock position
basophilic normoblast: some condensation & coarsening of nuclear chromatin
-blue cytoplasm
polychromatophilic normoblast: gray cytoplasm rather than blue 9combination of cytoplasmic RNA with hemoglobin)
-more condensed chromatin, smaller nucleus
orthochromatophilic normoblast: pink/gray cytoplasm (cytoplasmic hemoglobin begins to predominate)
- nucleus continues to decrease in size
- nucleus apoptoci and be extruded from cell
polychromatophil: young RBC (pinkish blue color)
- sent to peripheral blood 1 day before morphologically become mature erythrocytes
- larger than mature RBCs
reticulocyte: only seen using supravital stain
-probably identical to polychromatophil (reticular finers in cytoplasm)
mature erythrocyte: RBC: pink/red, no nucleus, central area of pallor
RBC shape variations

-spherocytes: spherical, densely staining, lack central pallor
ex) hereditary spherocytosis, autoimmune hemolytic anemia
-echinocytes (burr cells): short, regularly spaced projections
ex) chronic renal insufficiency
- schistocytes (keratocytes): traumatized, fragmented RBCs (evidence of intravascular hemolysis)
ex) thrombotic microangiopathic states; other mechanical trauma
-sickle cells (drepanocytes): long, narrow, curved RBCS that taper to a point
ex) sickle cell disease, sickle cell anemia
-target cells (codocytes): area of dense staining at center of central pallor (bull’s eye)
ex) small: thalassemias, hemoglobinopathies
large: liver disease, obstructive jaundice
-hemoglobin C: homozygotes exhibit target cells & rod-shaped crystals of hemoglobin C
-poikilocytosis: variation in RBC shape
inclusions in RBCs

RBC inclusions: abnormal substances inside of RBCS
-Howell-Jolly Bodies: dark purple, dense, round inclusions
- remnants of incompletely extruded nucleus
- often seen post splenectomy
-Heinz bodies: round inclusions that stain dark blue with supravital stains
- componsed of denatured hgb that binds to cytoplasmic tail of membrane proteins
ex) G6PD deficiency or unstable hemoglobins
(Heinz bodies only seen on supravital stain—light blue color)
-Basophilic stippling: presence of uniformly distributed punctate granules of dark blue
- darkly staining aggregates of ribosome s
ex) hgb synthesis defect (lead poisoning, sideroblastic anemia, thalassemia)
-malarial invasion of RBCs: presence of intracellular ring
sequence of neutrophil maturation

- promyelocyte: earliest neutrophil precursor in bone marrow
- large round cell with round nucleus
- myelocyte: large round cell, round nucleus, but more of cell is taken up by cytoplasm
- primary granules start to disappear
- clear area where golgi has formed on inside surface of nucleus
- metamyelocyte: adnvaced stage of myeloid maturation; kidney bean nucleus, more cytoplasm neutrophilic granules appearing, **transition between immature precursor cells an mature neutrophil (can be seen in blood in infection)
- band: almost mature neutrophil, horeshoe nucleus, neutorphilic granules in cytoplasm
- neutrophil: fully mature with fully segmented nucleus of 3-5 lobes

variants in neutrophils

-
hypersegmented: 6 or more distinct nuclear lobes
ex) megaloblastic anemia, myelodysplastic syndromes -
hyposegemented: 1 or 2 lobes
ex) myelodysplastic syndromes, Pelger-Huet anomaly
-toxic granulation: abundant dark primary granules in cytoplasm
ex) severe bacterial infection
-toxic vacuolization: when neutrophil accidentally dissolves itself with enzymes used to usually kill a bacteria
ex) severe bacterial infection
-Auer rods: seen in leukemic blasts of; aggregates of granular material that form elongated needles (fused lysosomes)
mononuclear cells in blood

- monocytes & lymphocytes (not granulocytes)
- small lymphocyte: adaptive immune system
- small nucleus with coarse consensed chromatin
- nucleus same size as normocytic RBC
-atypical (reactive) lymphocyte: abundant pale blue cytoplasm without granules; large round nucleus; edge of lymphyte often indented by surrounding RBCs
-associated with viral infections
-large granular lymphocyte (NK cells): cytotoxic lymphocyte that has prominent granules; part of innate immune system to reject tumors & cells infected by viruses
- kill by releasing contents of granules
- monocytes: mature in bone marrow & travel to tissues (macrophages)
- large cells with indented/folded nucleus; foamy cytoplasm; vaculoles (innate immune system)
organization of a lymph node

histo of lymph node

high endothelial venules in paracortex of lymph nodes

germinal center histo

functional anatomy of the spleen

histo of splenic white pulp

histo of spleen

what type of cell is this

mast cell
innate immunity (leukocyte)
what type of cell is this

neutrophil

what’s the difference between the these abscesses?

top: early abscess (acute inflammation)- filled with neutrophils
lower: much later (chronic inflammation) surrounded by granulation tissue
a unique stromal cell in thymus medulla



